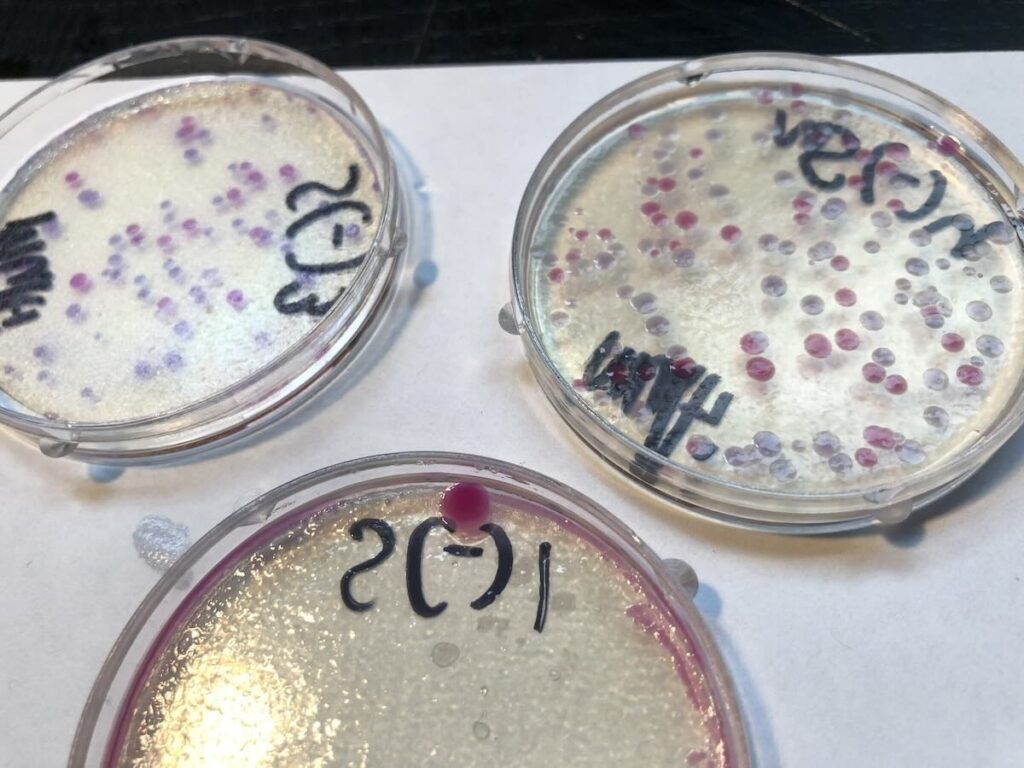

Hello! こんにちは !
My name is Pau Anta-Clusella, and I am a life scientist interested in exploring what can be created at the intersection of biology and engineering.
My early interest in science began through hands-on experimentation. At age 12, I modified my first cell and began learning the basics of genetic engineering. The following year, I was featured in a documentary on biohacking produced by Japan’s NHK. At 14, I designed and built a low-cost deep-sea drop camera capable of operating at depths of 500 meters. At 15, I began developing synthetic spider silk with electrical conductivity.
I am currently pursuing a Bachelor of Science in Biotechnology at Imperial College London. As part of my academic program, I am completing a year-long research placement at the Center for iPS Cell Research and Application (CiRA), Kyoto University, with the Osafune Lab, where I am gaining experience in stem cell biology and regenerative medicine, working with induced pluripotent stem cell technologies.
Outside the lab, I enjoy playing water polo, chess, and reading comics.